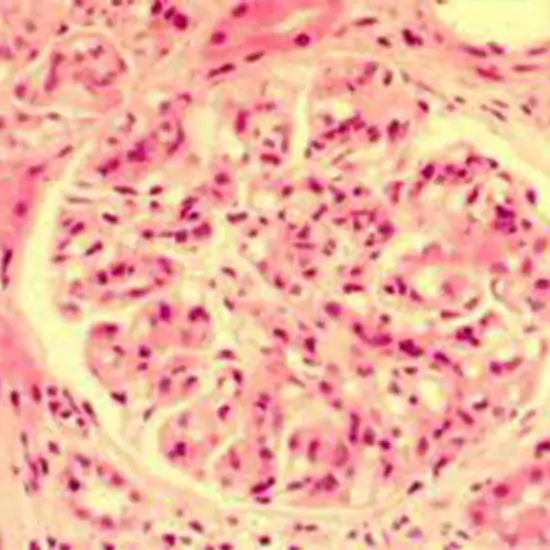

Book Cryoglobulins Screening Qualitative Appointment Online Near me at the best price in Delhi/NCR from Ganesh Diagnostic. NABL & NABH Accredited Diagnostic centre and Pathology lab in Delhi offering a wide range of Radiology & Pathology tests. Get Free Ambulance & Free Home Sample collection. 24X7 Hour Open. Call Now at 011-47-444-444 to Book your Cryoglobulins Screening Qualitative at 20% Discount.
Immunoglobulins are aberrant antibody proteins termed cryoglobulins. Colder than 98.6°F (37°C), cryoglobulins precipitate and separate from the blood solution. Cryoglobulins can obstruct tiny blood capillaries and limit blood flow. However, it is related to an abnormal protein production rate due to some underlying medical issue and can induce symptoms such as rashes, joint discomfort, and weakness.
Therefore, the relative number of cryoglobulins in the bloodstream must be tested to accurately diagnose medical diseases linked with increased cryoglobulin levels.
A cryoglobulins test measures the number of cryoglobulins in the blood. Cryoglobulinemia is diagnosed using a combination of assays. The tests ordered depend on the suspected illness.
A cryoglobulins test is ordered when someone has symptoms of cryoglobulinemia. Some examples are:
A needle is inserted into an arm vein to collect blood in a pre-warmed tube. During preparation, the sample is kept warm.
No preparation is needed. To reduce the risk of turbidity (cloudiness) in the sample due to triglycerides, an 8-hour fast before sample collection may be recommended.
Leave the dressing strip on for 15 minutes. No particular type of care is required.
The Cryoglobulins Qualitative Test cost varies INR 500 to INR 2500 to by region and facility. So constantly get tested at trustworthy diagnostic centres like Ganesh Diagnostic. It is staffed by trained and experienced professionals to assure patient and visitor safety.
| Test Type | Cryoglobulins Screening Qualitative |
| Includes | Cryoglobulins Screening Qualitative Test (Hormones) |
| Preparation | |
| Reporting | Within 24 hours* |
| Test Price |
₹ 700
|

Early check ups are always better than delayed ones. Safety, precaution & care is depicted from the several health checkups. Here, we present simple & comprehensive health packages for any kind of testing to ensure the early prescribed treatment to safeguard your health.